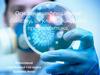
Основные инфекционные болезни, их классификация и профилактика

Похожие презентации:
Основные инфекционные болезни, их классификация и профилактика (урок № 21)
1.
Основные инфекционныеболезни,
их классификация и
профилактика
Выполнил:
преподаватель – организатор ОБЖ
Плашенков ДВ
2.
Учебные вопросы:1. Основные инфекционные болезни, их
классификация.
2. Виды иммунитета.
3. Профилактика инфекционных заболеваний.
3.
Инфекционные болезни этогруппа
болезней,
которые
вызываются
специфическими
возбудителями:
- болезнетворными бактериями;
- вирусами;
- простейшими грибками.
4.
Причины возникновенияинфекционной болезни внедрение в организм человека болезнетворных возбудителей и вступление их во
взаимодействие с
и тканями организма.
5.
Классификация основныхинфекционных болезней
Группы инфекционных болезней в
зависимости от локализации
возбудителя в организме и механизма
его передачи
Инфекционные болезни
Кишечные инфекции
Вирусный гепатит А, вирусный
гепатит Е, холера, дизентерия,
сальмонеллёз, ботулизм и др.
Инфекции дыхательных
путей
Дифтерия, грипп, туберкулёз, коклюш,
корь, ветряная оспа и др.
Кровяные инфекции
Сыпной тиф, вирусный гепатит В,
вирусный гепатит С, вирусный
гепатит D, ВИЧ – инфекция и др.
Инфекции наружных
покровов
Фурункулёз, карбункулы, рожа и др.
6.
Для возникновенияинфекционной болезни
необходимо:
объект
животное),
заражения
(человек
- наличие возбудителя,
- факторы передачи инфекции
или
7.
Основные пути передачи инфекцииПути распространения
инфекций
Фекально-оральный
Этим путем передаются все кишечные инфекции. Микроб с
калом, рвотными массами больного попадает на пищевые
продукты, воду, посуду, а затем через рот в желудочнокишечный тракт здорового человека
Воздушно-капельный
Этим путем распространяются все вирусные заболевания
верхних дыхательных путей. Вирус со слизью при чихании
или
разговоре
попадает
на
слизистые
верхних
дыхательных путей здорового человека.
8.
Пути распространенияинфекций
Жидкостный
Характерен для кровяных инфекций. Переносчиками этой
группы заболеваний служат кровососущие насекомые:
блохи, вши, клещи, комары и т.п.
Контактный или контактно-бытовой
Этим
путем
происходит
заражение
большинством
венерических заболеваний при тесном общении здорового
человека с больным
Зоонозные
Переносчиками зоонозных инфекций служат дикие и
домашние животные. Заражение происходит при укусах или
при тесном контакте с больными животными.
9.
Периоды развития болезниИНКУБАЦИОННЫЙ
период
НАЧАЛЬНЫЙ
период
Период ОСНОВНЫХ
ПРОЯВЛЕНИЙ болезни
Период УГАСАНИЯ
симптомов болезни
Выздоровление
10.
Инкубационный периодэто промежуток времени от момента
заражения
до
появления
первых
клинических симптомов заражения.
Для каждой инфекционной
болезни
существуют
определенные
пределы
продолжительности периода, которые могут составлять от нескольких часов
(при пищевых отравлениях) до одного года (при
бешенстве) и даже нескольких лет.
11.
Начальный периодсопровождается общими
проявлениями инфекционной болезни: недомоганием, часто ознобом, повышением температуры тела, головной болью, иногда тошнотой, т.е.
признаками болезни, не имеющими сколько – нибудь
чётких специфических особенностей.
Начальный период наблюдается не при всех
болезнях и длится, как правило, несколько
суток.
12.
Период основных проявленийболезни
характеризуется возникновением наиболее существенных и специфических
симптомов данной
болезни.
В этот период может наступить смерть
больного, или, если организм справился с действием возбудителя, болезнь
переходит в следующий период – выздоровление.
13.
Период угасаниясимптомов болезни
характеризуется постепенным исчезновением основных симптомов.
Клиническое выздоровление
совпадает
с
полным
жизнедеятельности организма.
почти никогда не
восстановлением
14.
Выздоровлениеможет быть полным, когда все нарушенные
функции организма восстанавливаются,
или
неполным,
если
сохраняются
остаточные явления.
15.
Профилактика инфекционныхзаболеваний
Подразумевает проведение предупредительных
мероприятий, направленных на повышение
иммунитета организма человека для поддержания
или выработки его невосприимчивости к
инфекционным болезням.
16.
Иммунитетэто невосприимчивость организма к
инфекционным и неинфекционным
агентам:
бактериям
вирусам
17.
«Любую болезнь легче предупредить,чем лечить»
Гиппократ

















 Медицина
Медицина